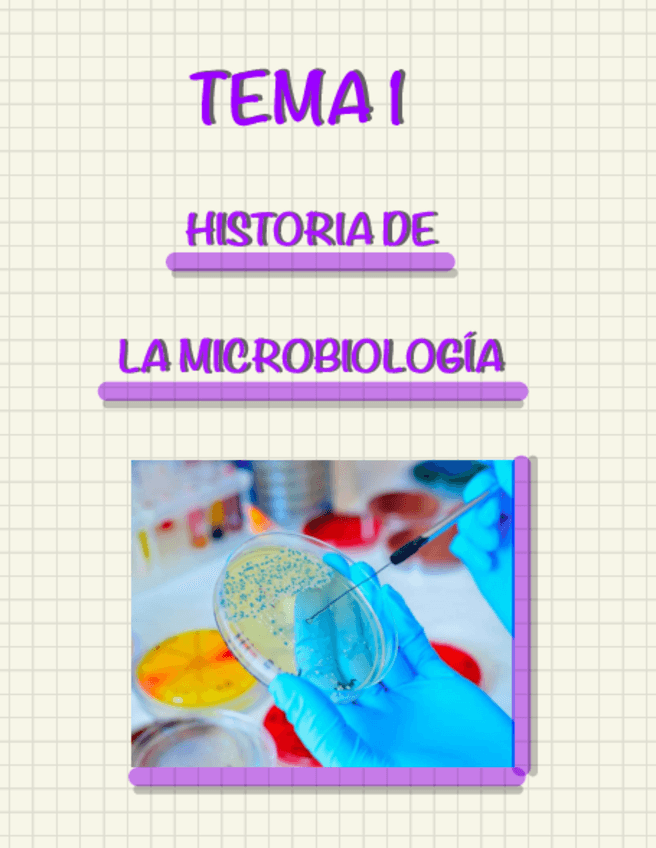

Microbiología
He publicado nuevos apuntes de 1º Microbiología: Tema-4.-Microbiologia.-1o-Biotecnologia.pdf
He publicado nuevos apuntes de 1º Microbiología: Tema-2.-Microbiologia.-1o-Biotecnologia.pdf
He publicado nuevos apuntes de 1º Microbiología: Tema-3.-Microbiologia.-1o-Biotecnologia.pdf
He publicado nuevos examenes de 1º Microbiología: Preguntas-microbiologia-examen.pdf
apuntes
-
Apuntes Microbiologia
He publicado nuevos apuntes de 1º Microbiología: Apuntes Microbiologia
apuntes
-
Microbiología Apuntes
He publicado nuevos apuntes de 1º Microbiología: Microbiología Apuntes
He publicado nuevos practicas de 1º Microbiología: Cuarderno-microbiologia.pdf
otros
-
Cuaderno microobiología
He publicado nuevos otros de 1º Microbiología: Cuaderno microobiología
He publicado nuevos apuntes de 1º Microbiología: RESUMEN-CUADERNILLO-TEMA-7.pdf
He publicado nuevos apuntes de 1º Microbiología: RESUMEN-CUADERNILLO-TEMA-6.pdf
He publicado nuevos apuntes de 1º Microbiología: RESUMEN-CUADERNILLO-TEMA-3.pdf
He publicado nuevos apuntes de 1º Microbiología: RESUMEN-CUADERNILLO-TEMA-4.pdf
He publicado nuevos apuntes de 1º Microbiología: RESUMEN-CUADERNILLO-TEMA-2.pdf
He publicado nuevos apuntes de 1º Microbiología: RESUMEN-CUADERNILLO-TEMA-1.pdf
He publicado nuevos apuntes de 1º Microbiología: TEMA-1-HISTORIA-DE-LA-MICROBIOLOGIA.pdf
He publicado nuevos apuntes de 1º Microbiología: Resumen-evaluacion-practicas-micro.pdf
He publicado nuevos apuntes de 1º Microbiología: MicrobiologiaTema1.pdf
He publicado nuevos practicas de 1º Microbiología: CUADERNO-PRACTICAS-PARTE-2.pdf
He publicado nuevos practicas de 1º Microbiología: CUADERNO-PRACTICAS-PARTE-1.pdf
He publicado nuevos apuntes de 1º Microbiología: RESUMEN-TEMA-7-MICRO.pdf
apuntes
-
TEMA-3-4-Y-5-RESUMEN-MEDIOS-CULTIVOS-CELULA-PROCARIOTA-Y-EUCARIOTA.-CONCEPTOS-ESENCIALES.pdf
He publicado nuevos apuntes de 1º Microbiología: TEMA-3-4-Y-5-RESUMEN-MEDIOS-CULTIVOS-CELULA-PROCARIOTA-Y-EUCARIOTA.-CONCEPTOS-ESENCIALES.pdf
He publicado nuevos apuntes de 1º Microbiología: Tema-1-Historia-De-La-Microbiologia.pdf
He publicado nuevos apuntes de 1º Microbiología: RESUMEN-TEMA-2-MICROSCOPIOS-TINCIONES-ESTERILIZACION-ETC.pdf
apuntes
-
APUNTES
He publicado nuevos apuntes de 1º Microbiología: APUNTES
apuntes
-
Apuntes microbiología
He publicado nuevos apuntes de 1º Microbiología: Apuntes microbiología
He publicado nuevos apuntes de 1º Microbiología: PreguntasPracticas.pdf
He publicado nuevos apuntes de 1º Microbiología: TEMA-1.-Historia-de-la-Microbiologia.pdf
He publicado nuevos practicas de 1º Microbiología: PRACTICAS-PREGUNTAS-DE-REVISION-VOLUNTARIAS.pdf
He publicado nuevos apuntes de 1º Microbiología: Preguntas-voluntarias-microbiologia.pdf
He publicado nuevos apuntes de 1º Microbiología: Preguntasvoluntarias.pdf
He publicado nuevos apuntes de 1º Microbiología: PREGUNTAS-VOLUNTARIAS-MICRO.pdf
He publicado nuevos practicas de 1º Microbiología: preguntas-practica-micro.-Alba-de-la-Torre-Ramos-2022-2023.pdf
apuntes
-
Microbiología
He publicado nuevos apuntes de 1º Microbiología: Microbiología
He publicado nuevos apuntes de 1º Microbiología: BATERIA-DE-PREGUNTAS-MICROBIOLOGIA.pdf
He publicado nuevos apuntes de 1º Microbiología: BATERIA-DE-PREGUNTAS-TEMA-6.pdf
He publicado nuevos apuntes de 1º Microbiología: Bateria-de-preguntas-Tema-1.pdf
He publicado nuevos apuntes de 1º Microbiología: Tema-7-clasificacion-de-los-microorganismos.pdf
He publicado nuevos apuntes de 1º Microbiología: Tema-5-Celula-eucariota-microbiana.pdf
He publicado nuevos examenes de 1º Microbiología: Preguntas-TEST-Microbiologia.pdf
apuntes
-
Resúmenes para perdidos - MICRO
He publicado nuevos apuntes de 1º Microbiología: Resúmenes para perdidos - MICRO
He publicado nuevos apuntes de 1º Microbiología: TEMA-4-CELULA-PROCARIOTA.pdf
He publicado nuevos apuntes de 1º Microbiología: TEMA-3-PARTE-2-MICROSCOPIA-Y-TINCIONES.pdf
He publicado nuevos apuntes de 1º Microbiología: TEMA-3-PARTE-1-MEDIOS-DE-CULTIVO.pdf
He publicado nuevos apuntes de 1º Microbiología: TEMA-2-TECNICAS-MICROBIOLOGICAS-BASICAS.pdf
He publicado nuevos apuntes de 1º Microbiología: ACTIVIDADES-PRACTICAS.pdf